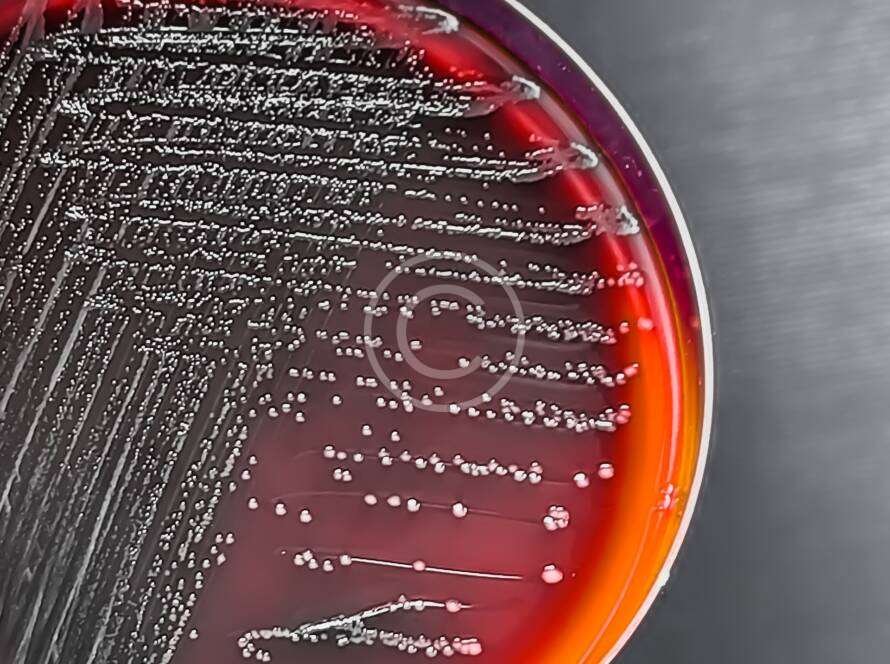

Sed ut perspiciatis unde omnis iste natus error
Sed ut perspiciatis unde omnis iste natus error
Sed ut perspiciatis unde omnis iste natus error
Sed ut perspiciatis unde omnis iste natus error
Sed ut perspiciatis unde omnis iste natus error
Sed ut perspiciatis unde omnis iste natus error
Sed ut perspiciatis unde omnis iste natus error
Sed ut perspiciatis unde omnis iste natus error
Sed ut perspiciatis unde omnis iste natus error
Sed ut perspiciatis unde omnis iste natus error